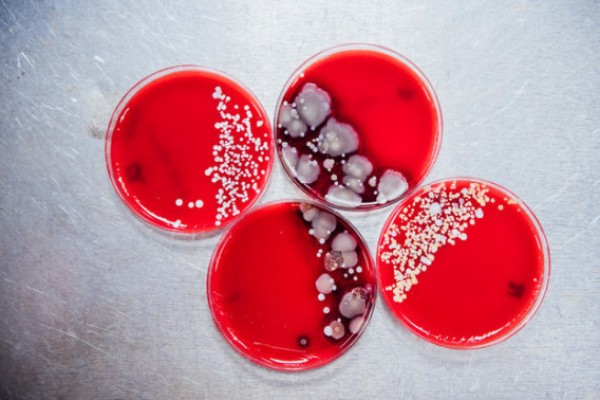

علمياً: كائنات مميتة تعيش على هاتفك الجوال.. هكذا تتخلص منها

رام الله - دنيا الوطن
أنواعٌ كثيرةٌ من الجراثيم تحيط بالبشر، معظمها غير ضار. لكن هناك ما يسمى بكتيريا “مسببات الأمراض”، التي يتضح من اسمها آثارها، والتي يجب علينا تجنبها.
الصحافية في موقع Buzz Feed كارولين كي، قامت بفحص هواتف زملائها، لكن هذه المرة بشكل غير معتاد، حيث ركزت على الكشف عن الجراثيم التي تعيش على هواتفهم الجوالة.
كارولين قامت بسحب 20 عينة من هواتف زملائها من أجل الكشف عليها في مختبر الميكروبات بالمركز الطبي في جامعة كولومبيا بنيويورك.
وقامت الدكتورة سوزان ويتير بتحليل العينات في "آغار"، وهي مادة شائعة الاستخدام في المختبرات تستخدم لتغذية الجراثيم والمحافظة عليها داخل أطباق "بتري".
انتظرت كارولين وويتير 3 أيام حتى تنمو الجراثيم داخل الأطباق وتصبح ظاهرةً للعين المجردة، بعدها فحصت ويتير العينات لمعرفة أي أنواع من الباكتيريا والفطريات والعفن التي تعيش على هاتف الشخص.
صدمة حقيقية!
اتضح من نتائج التحليل أن عينات جميع الهواتف التي وُضعت في الآجار نمت كلها، الأمر الذي لم تتوقعه كارولين.
وأوضحت كارولين أن ويتير قامت باختبار كميات وأنواع البكتيريا والفطريات والعفن، لكنها لم تختبر الفيروسات، مثل الإنفلوانزا والأمراض المنقولة جنسياً!
إليكم أنواع البكتيريا التي تم اكتشافها:
باكتيريا غير ضارة
كشف التحليل أن معظم الهواتف تحتوي على 5 أنواع من البكتيريا غير الضارة، التي تتواجد على الجلد والفم والأنف وفي البيئة، وهي:
Staphylococcus epidermidis الموجودة على جلد الإنسان وتنتقل على الهاتف من خلال اللمس، بكتيريا Micrococcus وهي نوع من البكتيريا يختلف من شخص لآخر، وتعلق على الهاتف عن طريق ملامسة الجلد للشاشة.
بالإضافة إلى بكتيريا Streptococcus viridans التي تعيش في الفم والحلق، وتنتقل إلى هاتفك من خلال أصابعك أو ملامسة فمك للهاتف أو السعال، وهي غالباً غير مضرة إلا إذا كانت بنسبة عالية في جسم الإنسان.
بكتيريا Moraxella وتأتي من الجيوب الأنفية، وقد تسبب مستويات عالية منها الإصابة بالتهابات مجرى الدم عند الأطفال وأصحاب المناعة الضعيفة، كما توجد بكتيريا Bacillusوتأتي من البيئة، والتي تعني أنك كنت في الخارج، وكثير منها يعني أن الهاتف قذر للغاية، لكنها لن تتسبب في إيذائك.
مسببات الأمراض
بعض الهواتف احتوت على "مسببات الأمراض"، وهي البكتيريا أو الفطريات أو الفيروسات التي تتسبب في الأمراض.
بكتيريا MRSA، وهي نوع من البكتيريا مقاوم للعديد من المضادات الحيوية، وقد يتسبب هذا النوع في الإصابة بإصابات حقيقية للجلد والأعضاء الداخلية، وقد يكون قاتلاً لأصحاب المناعة الضعيفة، وينتشر بسهولة بين الناس وعلى الأسطح، ويكون الشخص عرضة للإصابة بهذه البكتيريا إذا كان لديه جُرح مفتوح أو جهاز مناعي مثبط.
رغم هذا، تقول ويتير إن نسبة بسيطة من بكتيريا MRSA لا تتسبب في إصابة الأمراض إذا كان الشخص صاحب صحة جيدة.
كما تم العثور على بكتيريا staph، التي قد تتسبب في العديد من الأمراض، وتعيش هذه البكتيريا على الجلد وفي الجهاز التنفسي والأنف، ويحمل معظم الناس هذا النوع من البكتيريا دون مشاكل.
تقول ويتير، "قد يكون هذا مقلقاً، لأنه عندما تختلط هذه البكتيريا بجرح مفتوح، من الممكن أن تؤدي إلى إصابات في الدم والجلد، الذي قد ينتج عنه الدمامل والتسمم الغذائي والصدمات السامة وربما الموت، لكن مرة أخرى، يمكن البعض الناس أن يحمل هذه البكتيريا دون مشاكل".
بكتيريا E. coli، أو البكتيريا القاولونية، التي قد تكون سمعت عنها في مطاعم الوجبات السريعة، وهي في الحقيقة كائن برازي، أي تتواجد دائماً في البراز، كما تتواجد في الجهاز الهضمي مع بكتيريا المعدة، وقد تتواجد أيضاً على هاتفك إذا لم تغسل يديك بعد دخولك الحمام، أو قد يعلق في الحمام نتيجة رذاذ مياة المرحاض.
كما وجد على الهواتف خميرة Candida albicans، وهي غير منتشرة بكثرة، لكن لديها القابلية كي تكون من مسببات أمراض، وقد تتسبب في مرض القلاع أو عدوى الخميرة لدى أصحاب المناعة المثبطة والأطفال.
رغم هذا اطمئنوا
تقول ويتير، "إن كميات البكتيريا المسببة للأمراض على الهاتف تظل منخفضة؛ لذا تعتبر نسب الإصابة منخفضة بالنسبة للأشخاص الأصحاء والشباب".
وتضيف، "كما أنه من غير الواضح إذا كانت مسببات الأمراض كانت موجودة على جسم الإنسان طبيعياً أو انتقلت من شخص آخر إليه أو انتقلت إليه من الصالة الرياضية أو المكتب أو المترو".
وبحسب الباحثة الأميركية فإن على الناس أن لا تقلق جراء هذه النتائج، لكن بالتأكيد فإن من لديهم مسببات الأمراض على هواتفهم ربما يجب عليهم تنظيف هواتفهم في مرحلة ما، بالإضافة إلى غسل أيديهم بحرص.
كيف تحافظ على نظافة هاتفك؟
قم بسمح الهاتف بعد تعقيمه برذاذ الكحول المخفف، إذ تبين أن هاتف كارولين بعدما تم فحصه، والذي كانت تنظفه بهذا الشكل، لم يتواجد عليه أي من البكتيريا بما فيها مسببات الأمراض مثل staph.
وتنصح ويتير بتجنب استخدام مواد مثل المناديل المضادة للجراثيم أو السوائل التي قد تكون مضرة لشاشة الهاتف، في المقابل قالت إن رذاذ الكحول المخفف طريقة آمنة بنسبة 100% للحفاظ على نظافة الهاتف وكفاءته.
لكن ليس معنى تنظيف الهاتف مرة واحدة أن الجراثيم لن تتراكم عليه مرة أخرى، بل يجب تنظيفه بشكل منتظم، كما نصحت ويتير بعدم استخدام الهاتف في الحمام أو أثناء تناول الطعام.
إذا كنت لا تحب تنظيف هاتفك باستمرار، فيمكنك الاستعانة بجهاز phone soap، وهو جهاز يقضي على 99.9% من الجراثيم، من خلال وضع الهاتف داخل الجهاز، ومن ثمة تقوم الأشعة فوق البنفسجية بالقضاء على الجراثيم، ويتوافر الجهاز على موقع Amazon ويبلغ ثمنه 50 دولاراً.



أنواعٌ كثيرةٌ من الجراثيم تحيط بالبشر، معظمها غير ضار. لكن هناك ما يسمى بكتيريا “مسببات الأمراض”، التي يتضح من اسمها آثارها، والتي يجب علينا تجنبها.
الصحافية في موقع Buzz Feed كارولين كي، قامت بفحص هواتف زملائها، لكن هذه المرة بشكل غير معتاد، حيث ركزت على الكشف عن الجراثيم التي تعيش على هواتفهم الجوالة.
كارولين قامت بسحب 20 عينة من هواتف زملائها من أجل الكشف عليها في مختبر الميكروبات بالمركز الطبي في جامعة كولومبيا بنيويورك.
وقامت الدكتورة سوزان ويتير بتحليل العينات في "آغار"، وهي مادة شائعة الاستخدام في المختبرات تستخدم لتغذية الجراثيم والمحافظة عليها داخل أطباق "بتري".
انتظرت كارولين وويتير 3 أيام حتى تنمو الجراثيم داخل الأطباق وتصبح ظاهرةً للعين المجردة، بعدها فحصت ويتير العينات لمعرفة أي أنواع من الباكتيريا والفطريات والعفن التي تعيش على هاتف الشخص.
صدمة حقيقية!
اتضح من نتائج التحليل أن عينات جميع الهواتف التي وُضعت في الآجار نمت كلها، الأمر الذي لم تتوقعه كارولين.
وأوضحت كارولين أن ويتير قامت باختبار كميات وأنواع البكتيريا والفطريات والعفن، لكنها لم تختبر الفيروسات، مثل الإنفلوانزا والأمراض المنقولة جنسياً!
إليكم أنواع البكتيريا التي تم اكتشافها:
باكتيريا غير ضارة
كشف التحليل أن معظم الهواتف تحتوي على 5 أنواع من البكتيريا غير الضارة، التي تتواجد على الجلد والفم والأنف وفي البيئة، وهي:
Staphylococcus epidermidis الموجودة على جلد الإنسان وتنتقل على الهاتف من خلال اللمس، بكتيريا Micrococcus وهي نوع من البكتيريا يختلف من شخص لآخر، وتعلق على الهاتف عن طريق ملامسة الجلد للشاشة.
بالإضافة إلى بكتيريا Streptococcus viridans التي تعيش في الفم والحلق، وتنتقل إلى هاتفك من خلال أصابعك أو ملامسة فمك للهاتف أو السعال، وهي غالباً غير مضرة إلا إذا كانت بنسبة عالية في جسم الإنسان.
بكتيريا Moraxella وتأتي من الجيوب الأنفية، وقد تسبب مستويات عالية منها الإصابة بالتهابات مجرى الدم عند الأطفال وأصحاب المناعة الضعيفة، كما توجد بكتيريا Bacillusوتأتي من البيئة، والتي تعني أنك كنت في الخارج، وكثير منها يعني أن الهاتف قذر للغاية، لكنها لن تتسبب في إيذائك.
مسببات الأمراض
بعض الهواتف احتوت على "مسببات الأمراض"، وهي البكتيريا أو الفطريات أو الفيروسات التي تتسبب في الأمراض.
بكتيريا MRSA، وهي نوع من البكتيريا مقاوم للعديد من المضادات الحيوية، وقد يتسبب هذا النوع في الإصابة بإصابات حقيقية للجلد والأعضاء الداخلية، وقد يكون قاتلاً لأصحاب المناعة الضعيفة، وينتشر بسهولة بين الناس وعلى الأسطح، ويكون الشخص عرضة للإصابة بهذه البكتيريا إذا كان لديه جُرح مفتوح أو جهاز مناعي مثبط.
رغم هذا، تقول ويتير إن نسبة بسيطة من بكتيريا MRSA لا تتسبب في إصابة الأمراض إذا كان الشخص صاحب صحة جيدة.
كما تم العثور على بكتيريا staph، التي قد تتسبب في العديد من الأمراض، وتعيش هذه البكتيريا على الجلد وفي الجهاز التنفسي والأنف، ويحمل معظم الناس هذا النوع من البكتيريا دون مشاكل.
تقول ويتير، "قد يكون هذا مقلقاً، لأنه عندما تختلط هذه البكتيريا بجرح مفتوح، من الممكن أن تؤدي إلى إصابات في الدم والجلد، الذي قد ينتج عنه الدمامل والتسمم الغذائي والصدمات السامة وربما الموت، لكن مرة أخرى، يمكن البعض الناس أن يحمل هذه البكتيريا دون مشاكل".
بكتيريا E. coli، أو البكتيريا القاولونية، التي قد تكون سمعت عنها في مطاعم الوجبات السريعة، وهي في الحقيقة كائن برازي، أي تتواجد دائماً في البراز، كما تتواجد في الجهاز الهضمي مع بكتيريا المعدة، وقد تتواجد أيضاً على هاتفك إذا لم تغسل يديك بعد دخولك الحمام، أو قد يعلق في الحمام نتيجة رذاذ مياة المرحاض.
كما وجد على الهواتف خميرة Candida albicans، وهي غير منتشرة بكثرة، لكن لديها القابلية كي تكون من مسببات أمراض، وقد تتسبب في مرض القلاع أو عدوى الخميرة لدى أصحاب المناعة المثبطة والأطفال.
رغم هذا اطمئنوا
تقول ويتير، "إن كميات البكتيريا المسببة للأمراض على الهاتف تظل منخفضة؛ لذا تعتبر نسب الإصابة منخفضة بالنسبة للأشخاص الأصحاء والشباب".
وتضيف، "كما أنه من غير الواضح إذا كانت مسببات الأمراض كانت موجودة على جسم الإنسان طبيعياً أو انتقلت من شخص آخر إليه أو انتقلت إليه من الصالة الرياضية أو المكتب أو المترو".
وبحسب الباحثة الأميركية فإن على الناس أن لا تقلق جراء هذه النتائج، لكن بالتأكيد فإن من لديهم مسببات الأمراض على هواتفهم ربما يجب عليهم تنظيف هواتفهم في مرحلة ما، بالإضافة إلى غسل أيديهم بحرص.
كيف تحافظ على نظافة هاتفك؟
قم بسمح الهاتف بعد تعقيمه برذاذ الكحول المخفف، إذ تبين أن هاتف كارولين بعدما تم فحصه، والذي كانت تنظفه بهذا الشكل، لم يتواجد عليه أي من البكتيريا بما فيها مسببات الأمراض مثل staph.
وتنصح ويتير بتجنب استخدام مواد مثل المناديل المضادة للجراثيم أو السوائل التي قد تكون مضرة لشاشة الهاتف، في المقابل قالت إن رذاذ الكحول المخفف طريقة آمنة بنسبة 100% للحفاظ على نظافة الهاتف وكفاءته.
لكن ليس معنى تنظيف الهاتف مرة واحدة أن الجراثيم لن تتراكم عليه مرة أخرى، بل يجب تنظيفه بشكل منتظم، كما نصحت ويتير بعدم استخدام الهاتف في الحمام أو أثناء تناول الطعام.
إذا كنت لا تحب تنظيف هاتفك باستمرار، فيمكنك الاستعانة بجهاز phone soap، وهو جهاز يقضي على 99.9% من الجراثيم، من خلال وضع الهاتف داخل الجهاز، ومن ثمة تقوم الأشعة فوق البنفسجية بالقضاء على الجراثيم، ويتوافر الجهاز على موقع Amazon ويبلغ ثمنه 50 دولاراً.

التعليقات